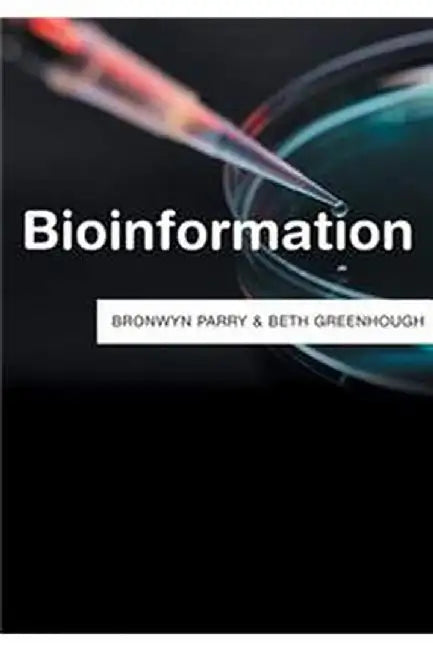
Bioinformation by Bronwyn Parry, Beth Greenhough

political science > international relations / trade & tariffs

Bioinformation
Ships in 1-2 Days
Free Shipping in India on orders above Rs. 500
Ships in 1-2 Days
Free Shipping in India on orders above Rs. 500
About the Book From DNA sequences stored on computer databases to archived forensic samples and biomedical records, bioinformation comes in many forms. Its unique provenance - the fact that it is 'mined' from the very fabric of the human body - makes it a mercurial resource; one that no one seemingly owns, but in which many have deeply vested interests.
Who has the right to exploit and benefit from bioinformation? The individual or community from whom it was derived? The scientists and technicians who make its extraction both possible and meaningful or the commercial and political interests which fund this work? Who is excluded or even at risk from its commercialisation? And what threats and opportunities might the generation of 'Big Bioinformational Data' raise?
In this groundbreaking book, authors Bronwyn Parry and Beth Greenhough explore the complex economic, social and political questions arising from the creation and use of bioinformation. Drawing on a range of highly topical cases, including the commercialization of human sequence data; the forensic use of retained bioinformation; biobanking and genealogical research, they show how demand for this resource has grown significantly driving a burgeoning but often highly controversial global economy in bioinformation. But, they argue, change is afoot as new models emerge that challenge the ethos of privatisation by creating instead a dynamic open source 'bioinformational commons' available for all future generations.
Bronwyn Parry is Professor in the Department of Global Health and Social Medicine at King's College, London.
Beth Greenhough is Associate Professor in Human Geography at the School of Geography and the Environment, University of Oxford.
• Author(s): Clear | James • Publisher: Penguin • Publisher Imprint: Penguin Random House • Subject: General Books
• Author(s): Jeff Kinney • Publisher: Penguin Random House Children's UK • Publisher Imprint: Penguin Random House Children's UK • BISAC: Comics & Graphic Novels - Humorous
• Author(s): Ichiro Kishimi • Publisher: GROVE ATLANTIC • Publisher Imprint: Allen & Unwin • BISAC: Personal Growth - SuccessIchiro Kishimi lives in Kyoto. He writes, lectures and teaches in psychiatric clinics as a certified counsellor and c...
View full details• Author(s): Chetan Bhagat • Publisher: HarperCollins Publishers India • Publisher Imprint: HarperCollins Publishers India • BISAC: GeneralFrom India's top-selling writer Chetan Bhagat comes a powerful new love story that will make you laugh, cry...
View full details• Author(s): Brianna Wiest • Publisher: Manjul Publishing • Publisher Imprint: Amaryllis • BISAC: Body Mind And SpiritThis is a book about self-sabotage. Why we do it, when we do it, and how to stop doing it—for good. Coexisting but conflicting n...
View full details• Author(s): Morgan Housel • Publisher: Pan Macmillan • Publisher Imprint: Pan Macmillan • BISAC: Finance - Wealth ManagementA third book from the International bestselling author of The Psychology of Money and Same as Ever, lessons on harnessing...
View full details• Author(s): Arundhati Roy• Publisher: PRH INDIA LOCAL PRINT• Publisher Imprint: Penguin Hamish Hamilton• BISAC: Literary FiguresArundhati Roy’s first work of memoir, this is a soaring account, both intimate and inspiring, of how the author became...
View full details• Author(s): Acharya Prashant • Publisher: HarperCollins Publishers India • Publisher Imprint: HarperCollins Publishers India • BISAC: GeneralIn a world where vagueness is mistaken for depth and obscurity passes for wisdom, Truth without Apology ...
View full details• Author(s): Sudha Murthy • Publisher: India Puffin • Publisher Imprint: India Puffin • BISAC: Short StoriesWho can resist a good story, especially when it's being told by Grandma? From her bag emerges tales of kings and cheats, monkeys and mic...
View full details• Author(s): Satoshi Yagisawa • Publisher: Bonnier Books Ltd • Publisher Imprint: Bonnier Books Ltd
• Author(s): Newport, Cal • Publisher: Little, Brown Book Group • Publisher Imprint: Piatkus
• Author(s): Shrijeet Shandilya • Publisher: Ebury Press • Publisher Imprint: Ebury Press • BISAC: Romance - GeneralIn the electric haze of college life, three friends are bound by laughter, late-night talks and unspoken promises. But when two of...
View full details• Author(s): Dan Brown • Publisher: Transworld Publishers Ltd • Publisher Imprint: Transworld Publishers Ltd • BISAC: Thrillers - EspionageDan Brown is the bestselling author of Digital Fortress, Deception Point, Angels and Demons, The Da Vinci C...
View full details• Author(s): Sudha Murty • Publisher: India Puffin • Publisher Imprint: India Puffin • BISAC: Action & Adventure - General
 Rich Dad Poor Dad: What the Rich Teach Their Kids about Money That the Poor and Middle Class Do Not!
Rich Dad Poor Dad: What the Rich Teach Their Kids about Money That the Poor and Middle Class Do Not!
• Publisher: Penguin • Publisher Imprint: Penguin Random House • Subject: General Books • BISAC: Personal Finance - GeneralApril of 2022 marks a 25-year milestone for the personal finance classic Rich Dad Poor Dad that still ranks as the #1 Pers...
View full details• Author(s): Dale Carnegie | Napoleon Hill • Publisher: Fingerprint • Publisher Imprint: Fingerprint • Subject: General Books
• Author(s): Freida Mcfadden • Publisher: Penguin Select Print • Publisher Imprint: Penguin Select Publishing"Multi-Million Copy Bestselling Series •Now Being Made Into a Major Motion Picture Starring Sydney Sweeney and Amanda Seyfried #1 New Yor...
View full details• Author(s): Wonder House Books • Publisher: Wonder House Books • Publisher Imprint: Wonder House Books • BISAC: Comics & Graphic Novels - Fairy Tales, Folklore, Legends & MTimeless Wisdom, Talking Animals & Life Lessons for Young Min...
View full details• Author(s): Viktor E. Frankl • Publisher: Random House • Publisher Imprint: Random Hou • Subject: Medical, Nursing and Health Sciences
• Author(s): Madhavi Bharadwaj • Publisher: PRH India • Publisher Imprint: Penguin Ebury Press • BISAC: Parenting - MotherhoodWelcome to the wild, messy, wonderful world of parenting--where the nights are long, the diapers are explosive, and unso...
View full details• Author(s): Vir Das • Publisher: HarperCollins Publishers India • Publisher Imprint: HarperCollins Publishers India • BISAC: Entertainment & Performing ArtsComedian and actor Vir Das is beloved (by some, tolerated by others, blocked by a few...
View full details• Author(s): Eric Carle • Publisher: Penguin Books, Limited (UK) • Publisher Imprint: Penguin Books, Limited (UK) • BISAC: Animals - Butterflies, Moths & CaterpillarsEric Carle's The Very Hungry Caterpillar is a perennial favourite with child...
View full details• Author(s): Prajakta Koli • Publisher: Harper Fiction India • Publisher Imprint: Harper Fiction India • BISAC: Romance - ContemporaryWinner of the Amazon India Popular Choice Debut Book 2025 Award. From one of India's most-loved creators comes s...
View full details